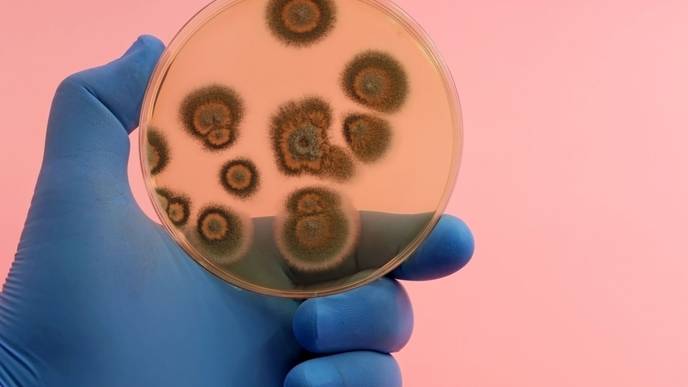
ReachMD Healthcare Image

Leading Valley Fever Expert Shares ‘State-of-the-Art’ Knowledge About Fungal Disease
A University of Arizona College of Medicine – Tucson researcher and internationally recognized expert on Valley fever co-authored a review paper, published earlier this month in the New England Journal of Medicine, that focuses on how fungal diseases present in people with healthy immune systems and examines current diagnostics and treatments.
The New England Journal of Medicine invited John N. Galgiani, MD, director of the Valley Fever Center for Excellence at the UArizona College of Medicine – Tucson, to summarize the current body of knowledge about endemic fungal diseases. Along with Carol A. Kauffman, MD, of the University of Michigan Medical School, Galgiani focused on the two most common fungal diseases endemic to the United States: Valley fever and histoplasmosis.
“In 2019, of 21,425 cases of endemic fungal disease reported to the Centers for Disease Control and Prevention, 20,061 were due to Valley fever and 1,124 to histoplasmosis,” Galgiani said. “We focused on these two because they are by far the most common.”
Valley fever, medically known as coccidioidomycosis, is a fungal infection native to the western U.S., especially Arizona and California. The review explains where Coccidioides, the fungus that causes Valley fever, is found. For persons who live in or have recently visited those endemic parts of the western states, awareness by them and their physicians about Valley fever and its symptoms will make early diagnosis more likely.
“Summarizing the current knowledge about these diseases is important in expanding awareness among practicing physicians,” Galgiani said. “Even where Valley fever is common, like Arizona, doctors very frequently forget to look for it. Fortunately, more than 90% of Valley fever patients get better without treatment, but for others, it can be debilitating, usually taking many weeks to months to go away. During that time, doctors often prescribe antibiotics, which don’t help, and may order many more X-rays and other tests. Unnecessary surgical procedures might even take place. That’s why it’s so important to get an early diagnosis – there is a whole lot of medicine and testing that you don’t need once you get the right diagnosis.”
The review describes the course of Valley fever, which is caused by inhaling fungal spores lurking in the environment. About one-third of people who are infected develop symptoms, which take about 1 to 3 weeks to appear and resemble community-acquired pneumonia. Symptoms may persist for weeks or months, and in some patients, the infection will spread to other parts of the body, such as the brain, skin or bones.
The paper also examined the current diagnostic tests used to detect Valley fever and when the disease should be treated with antifungal drugs. Galgiani, who also is a member of the university’s BIO5 Institute, says better diagnostics are needed to fight Valley fever.
“It takes days or even weeks, depending where you live, for a Valley fever blood test result to come back,” Galgiani said. “If we had a point-of-care test, it’d be a game changer because the right management could start right then.”
Finally, the review summarizes recent advances in developing a Valley fever vaccine. Research spearheaded by collaborators at the Valley Fever Center for Excellence has led to a potential Valley fever vaccine for dogs that is under review for veterinary use. If approved, it will be the world’s first vaccine against a fungal infection. This same vaccine could be reformulated to eventually lead to a vaccine to protect people, Galgiani said.
Kauffman’s contributions to the review focused on her area of expertise, histoplasmosis, which is native to central and eastern states, especially in the Ohio and Mississippi River valleys.
Being invited to put together a review article is a high honor, especially when the request comes from a high-impact publication such as the New England Journal of Medicine, widely recognized as the top medical journal in the world. It is the journal’s first review of Valley fever since 1995, when they published an article by David A. Stevens, MD. Stevens was Galgiani’s mentor at Stanford University School of Medicine, where Galgiani completed a fellowship in infectious diseases prior to joining the College of Medicine – Tucson in 1978.
“Almost nobody was working on Valley fever in Arizona – it was not something Arizonans paid attention to in 1978. I think that is gradually changing,” said Galgiani, who helped found the Valley Fever Center for Excellence in 1996. “Since two-thirds of all Valley fever infections come from Arizona, there is no place else in the country where it makes more sense to have a center focused on this disease.”